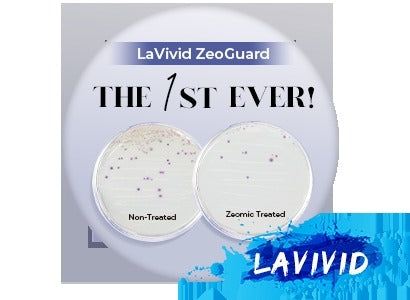
Transforming Hair Replacement: The Impact of Antimicrobial Technologies on Men's Grooming

- Introduction
The world of men’s hair replacement is evolving rapidly, with hygiene and comfort increasingly taking center stage. While men have long sought reliable, natural-looking hair systems, today’s discerning consumers also demand options that support scalp health and prevent discomfort. Enter antimicrobial technologies, a revolutionary advancement in hair care that addresses these needs by actively inhibiting bacterial growth, reducing odors, and extending the lifespan of hair systems. Let’s learn about antimicrobial mens hair replacement !
Among these groundbreaking innovations is Zeomic technology—a silver-based antimicrobial treatment that provides a high level of hygiene, comfort, and confidence to wearers. This technology has been integrated into advanced systems like the Zeo-Mirage Antimicrobial Hair Replacement System for Men, offering a state-of-the-art blend of natural aesthetics and durability.

- Understanding Antimicrobial Technologies
Antimicrobial properties in hair replacement systems help control the growth of bacteria, mold, and fungi, effectively preventing unpleasant odors and itching. These properties are crucial for anyone wearing a hairpiece daily, especially in active lifestyles where sweat and heat can contribute to bacterial build-up.
Zeomic Technology is an industry-leading innovation, utilizing silver ions that effectively target and inhibit the metabolic activity of microbes on the hairpiece base. Unlike some organic antimicrobials, silver-based Zeomic offers long-lasting protection and is a staple in products like Zeo-Single Knot Mirage Antibacterial Hair System, where it combats bacterial growth and preserves cleanliness.

- Benefits of Antimicrobial Hair Systems
Antimicrobial men’s hair replacement systems bring substantial benefits that enhance both comfort and confidence.
Health and Hygiene
These advanced hair systems work actively to reduce microbial growth on the scalp. For example, Zeo-Mirage integrates Zeomic additives into its base, creating a hygienic environment that minimizes the risk of scalp issues and reduces odors. By inhibiting bacterial growth, antimicrobial systems ensure a consistently fresh and sanitary experience, giving wearers the freedom to go about their daily lives without discomfort.
Durability and Maintenance
Antimicrobial technologies also contribute to the longevity of hair systems. Zeomic technology, found in both Zeo-Mirage and Zeo-Single Knot Mirage, makes maintenance more manageable by reducing bacterial build-up, which can lead to faster deterioration of materials. The Zeo-Single Knot Mirage, with its durable single knot design, ensures minimal shedding and extended wearability compared to traditional systems, making it a valuable investment.
- Innovative Designs and Materials
Today’s hair replacement systems come with advanced design features and material compositions that promote comfort, aesthetics, and hygiene.
Zeo-Mirage and Zeo-Single Knot Mirage hair systems exemplify these modern innovations. Zeo-Mirage boasts an ultra-thin skin base of only 0.04 to 0.06 mm, achieving a natural look that seamlessly blends with the scalp. This transparency gives an “undetectable” effect, creating the appearance that hair is growing directly from the scalp—a significant benefit for those seeking the most realistic look possible.
Additionally, Zeo-Single Knot Mirage features a 0.06 to 0.08 mm full thin skin construction with single split knots, which is not only comfortable but also versatile for styling. Both products represent a leap forward in hair replacement, with antimicrobial technology woven into their foundations for a healthier, cleaner, and more comfortable experience.
- User Experience and Satisfaction
The impact of antimicrobial hair systems on self-esteem and user satisfaction is transformative. No longer do users have to worry about the discomfort associated with bacterial growth, odors, or frequent maintenance. Testimonials from wearers reveal a significant improvement in the quality of life when using systems with Zeomic treatment.
For instance, clients who tested Zeo-Mirage reported loving its lightweight feel and the lasting quality of the hair, even after weeks of wear. Another customer mentioned that the Zeo-Single Knot Mirage provided unparalleled durability, with minimal shedding and ease of cleaning. Such feedback highlights how antimicrobial hair systems are redefining user experience in the hair replacement industry.
- Future Trends in Antimicrobial Hair Replacement
The future of men’s hair replacement is packed with exciting advancements. Emerging materials and improved antimicrobial treatments will continue to enhance the hygiene, comfort, and durability of these systems.
The demand for customized, comfortable, and health-conscious products is also driving innovation. We can expect to see further developments in thin skin bases, advanced antimicrobial agents, and personalized options that cater to diverse needs and preferences. The integration of antimicrobial technologies like Zeomic will likely expand, offering more people access to quality hair systems that support their lifestyles.
- Challenges and Considerations
Though antimicrobial hair systems provide substantial benefits, they do come with considerations. The cost of materials like Zeomic-treated thin skin or mono bases can make these products more expensive than standard options. It’s also essential for consumers to understand the health benefits versus perceived marketing claims around antimicrobial technology. Consulting with a professional can help in choosing the best system based on personal needs and budget.
To optimize the longevity and efficacy of systems like Zeo-Mirage and Zeo-Single Knot Mirage, regular cleaning and maintenance are crucial. These products, while advanced, still require some level of care to keep their antimicrobial properties active and effective over time.
- Conclusion
Innovations in antimicrobial men’s hair replacement are shaping the future of hair care, prioritizing health, hygiene, and comfort in every detail. Products like the Zeo-Mirage Antimicrobial Hair Replacement System and Zeo-Single Knot Mirage Antibacterial Hair System showcase the power of advanced technology in enhancing men’s grooming experiences. With antimicrobial protection, these systems offer not only a realistic look but also unmatched comfort and hygiene, making them ideal choices for today’s modern man.
For those considering hair replacement options, the advantages of antimicrobial technologies in promoting a cleaner, fresher, and more natural wearing experience cannot be overstated. Explore the options available, consult with a professional, and take the step toward a future where style and health go hand in hand.